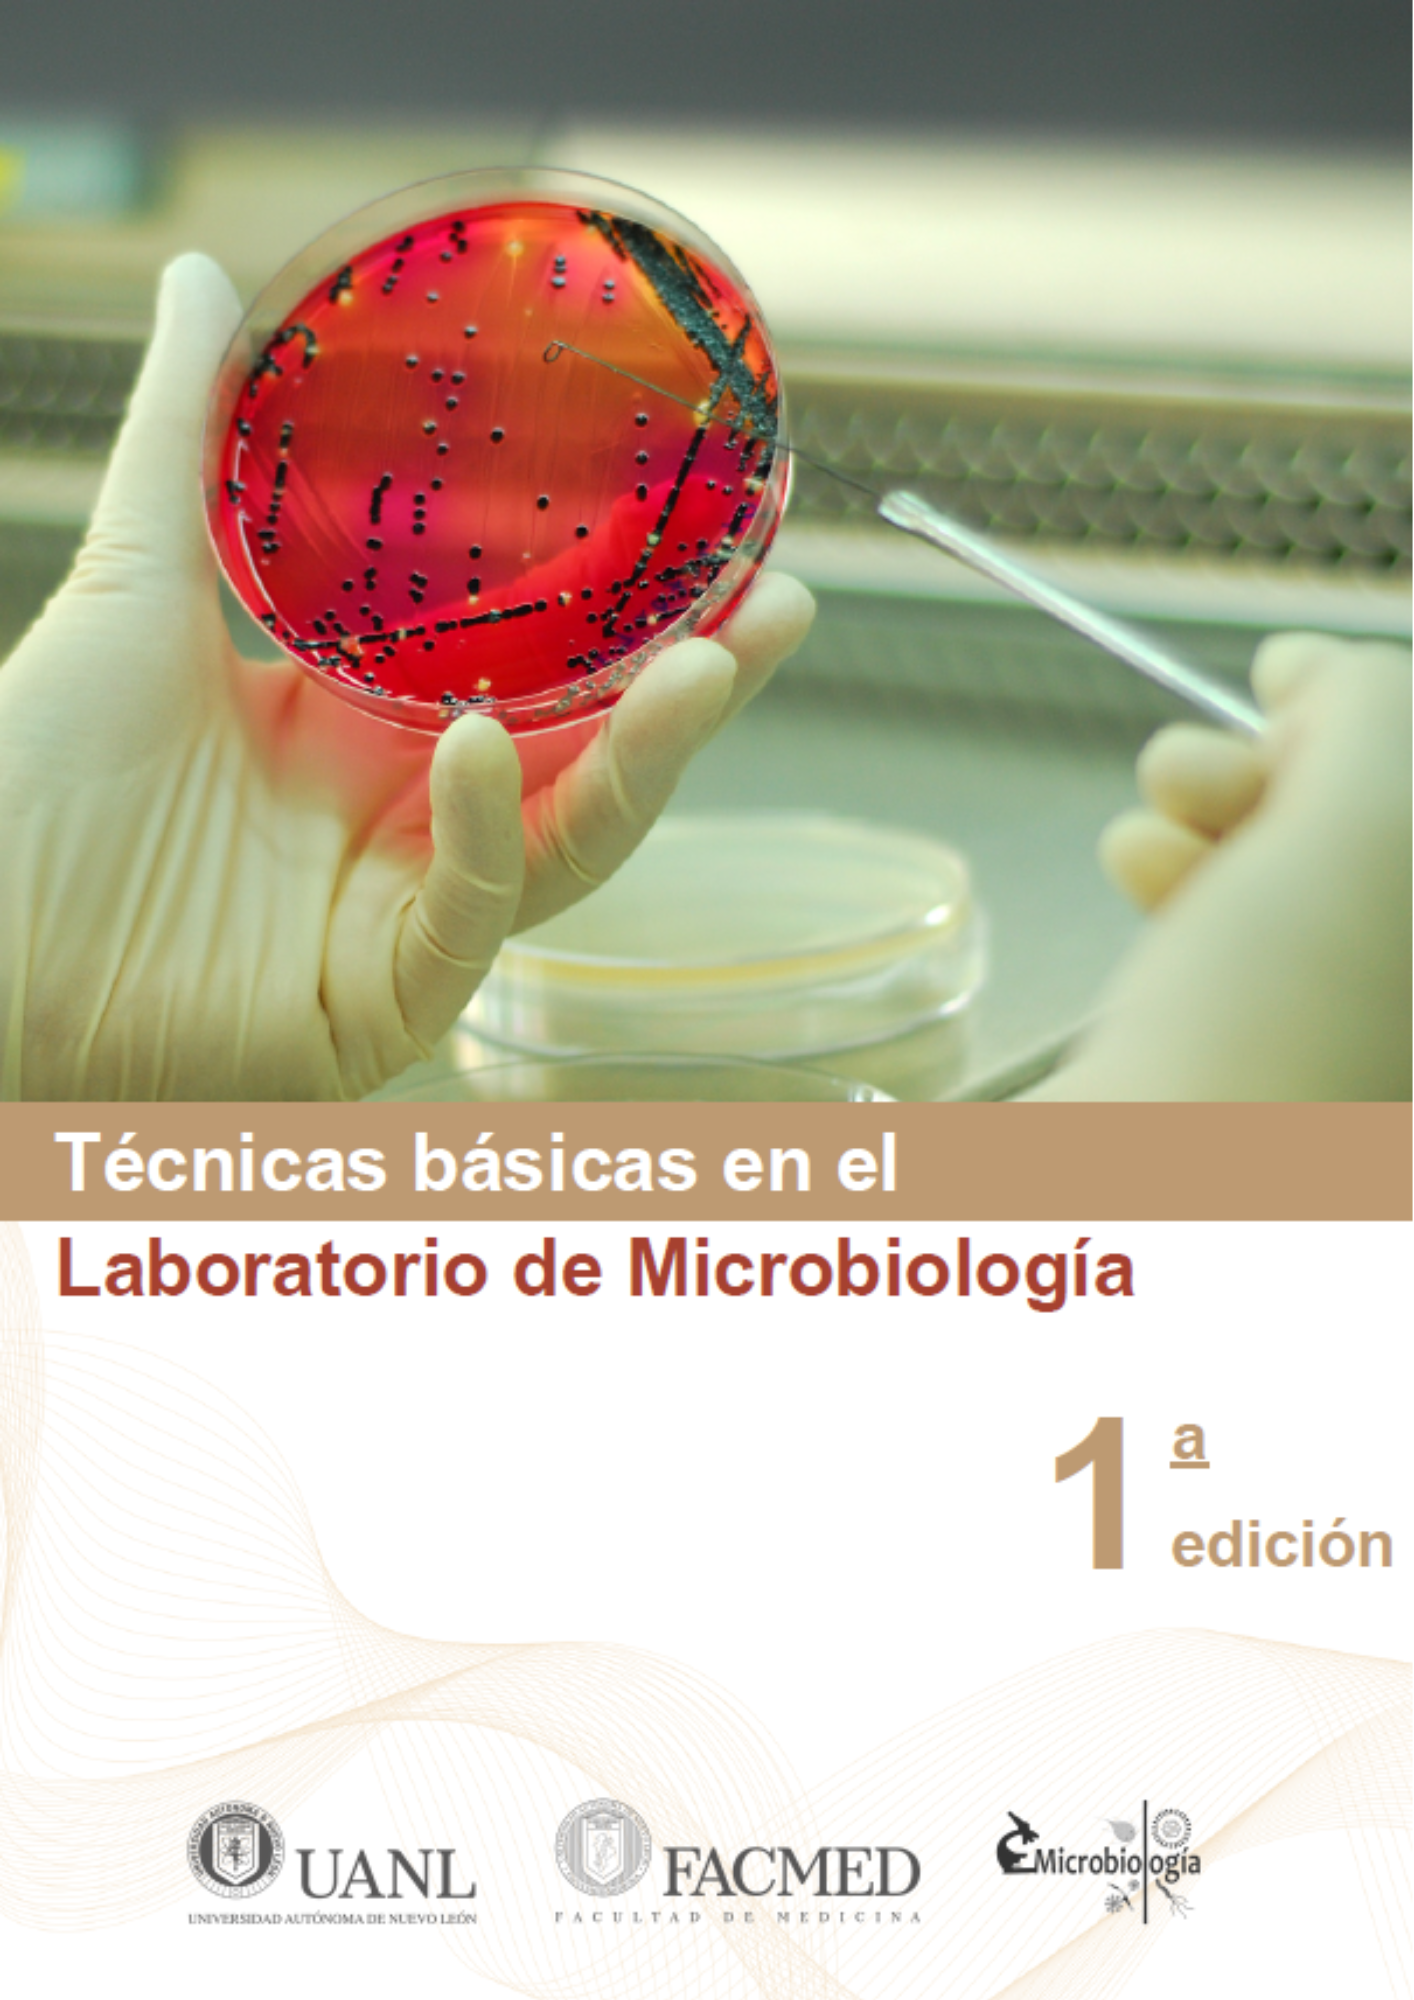

¡Tu carrito está actualmente vacío!
Técnicas Básicas en el Laboratorio de Microbiología
Versión digital en PDF del manual «Técnicas básicas en el laboratorio de microbiología». Una guía ilustrada y accesible para aprender los procedimientos esenciales del trabajo microbiológico. Ideal para estudiantes que inician su formación en el laboratorio clínico. ¡Descarga inmediata!
Descripción
Técnicas básicas en el laboratorio de microbiología (versión digital – PDF)
Tu guía esencial para iniciar con seguridad y precisión el trabajo en el laboratorio de microbiología clínica.
Este manual digital ha sido cuidadosamente elaborado por el Departamento de Microbiología de la Facultad de Medicina de la UANL para proporcionar una introducción clara y sistemática a las técnicas fundamentales del laboratorio microbiológico. Pensado como un recurso formativo para estudiantes de nivel inicial, este texto permite comprender desde cero el manejo de materiales, equipo, muestras biológicas y procedimientos básicos bajo condiciones de bioseguridad.
📘 Contenido del libro:
- Fundamentos del trabajo microbiológico: tipos de microorganismos, niveles de bioseguridad, zonas de riesgo y normas oficiales aplicables (NOM-087-ECOL-SSA1-2002).
- Identificación y uso adecuado del material y equipo de laboratorio: tubos, frascos, gradillas, mechero, microscopio, autoclave, entre otros.
- Técnicas básicas: lavado de manos, colocación y retiro de bata y guantes, desinfección de superficies, recolección de muestras clínicas.
- Principios de siembra microbiológica: manejo de medios de cultivo, técnicas de estría, siembra por agotamiento y en profundidad.
- Observación microscópica: preparación de montajes húmedos, tinción de Gram, KOH, Lugol, azul de lactofenol, entre otras.
- Actividades prácticas con instrucciones paso a paso, ilustraciones, hojas de observación y espacios para registrar resultados.
💻 Ventajas de la versión digital:
- Acceso inmediato tras la compra.
- Portátil y compatible con cualquier dispositivo: computadora, tablet o smartphone.
- Ideal para impresión por secciones según necesidad práctica.
- Formato PDF compatible con lectores estándar.
🎯 Dirigido a:
Estudiantes de Química Clínica, Medicina, Microbiología y áreas afines que inician su formación en el laboratorio clínico, así como docentes que requieren una herramienta pedagógica clara, accesible y estructurada para sus cursos introductorios.
📄 Formato:
Archivo digital en PDF | 144 páginas | Descarga inmediata